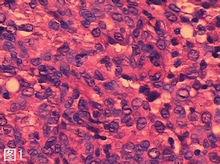
病毒致癌因子

簡介
病毒致癌因子
病毒致癌因子能使細胞癌變的病毒叫做病毒致癌因子。是三種致癌因子之一:物理致癌因子、化學致癌因子、病毒致癌因子。
致癌機制
致癌病毒能夠引起細胞發生癌變,主要是因為他們含有病毒癌基因以及與之有關的核酸序列。它們感染人的細胞後,將其基因組整合進入人的基因組中,成為原病毒而起著癌基因的作用,從而誘發人的細胞癌變。
致癌病毒與細胞DNA相互作用可以引起細胞染色體改變,DNA病毒感染人體細胞後,病毒的DNA與人體細胞的DNA整合,使細胞轉化為腫瘤細胞。RNA病毒含有依賴RNA的DNA多聚酶(逆轉錄酶),能將病毒的RNA作為模板,合成具有病毒遺傳信息的DNA,即為前病毒。前病毒與人體細胞DNA整合,使細胞轉化為腫瘤細胞。癌基因由細胞本身攜帶,是一類能使人體細胞發生癌變的DNA序列,存在於正常細胞基因組中的癌基因稱為原癌基因。在人體免疫機能正常時,癌基因處於靜止狀態。人體的免疫監視是控制細胞突變的最主要方式。當人體免疫機能由於某種原因下降時,又受到致腫瘤病毒感染,激活了癌基因,使其高效表達,產生大量轉化蛋白,使正常細胞轉化為腫瘤細胞。所有腫瘤病毒引起腫瘤或細胞轉化都是經過癌基因實現的。逆轉錄病毒中的癌基因原本來源於原癌基因。當逆轉錄病毒的基因整合到細胞基因組,通過重排或重組,將細胞的原癌基因組轉導至病毒的基因組,使原來的野生型病毒轉變為攜帶轉化癌基因病毒,從而獲得了致癌性質。病毒因子的致癌作用,只發生在癌瘤發展的早期,細胞癌基因的表達和激活並不需要病毒的持續作用。人類腫瘤病毒致癌需要很長潛伏期,需要感染很多細胞,而且只有少數感染細胞變成腫瘤細胞。
關係
病毒因子致癌,是腫瘤基礎研究中的一個熱點。現代已知RNA病毒中的乳頭瘤病毒和人的宮頸癌有關;單純皰疹病毒也和宮頸癌有關;EB病毒和某種淋巴瘤、鼻咽癌有關;B肝和C肝病毒則和肝癌有關;而RNA病毒中的T細胞白血病病毒則和某些白血病有關;愛滋病的病毒,也和人的癌腫有關。
主要種類
1.RNA 病毒
1.1 HTLV1 型病毒與成人 T 細胞白血病 - 淋巴瘤 (adult T-cell leukemia-lymphoma , ATLL)。HTLV1型病毒屬於逆轉錄病毒科RNA致腫瘤病毒亞科,是一種外源性C型病毒。病毒RNA由9.0kb核苷酸組成,包括兩端的長末端重複序列和4個主要的開放讀碼框架(ORF),結構基因的序列為5′-gag-pol-env-px-3′。gag編碼毒粒的結構蛋白,pol編碼病毒的逆轉錄酶,env編碼病毒的包膜蛋白,px編碼調節蛋白。HTLV1型以前病毒DNA形式整合到宿主細胞DNA,病毒不含有癌基因,但能編碼兩種蛋白:tax和rex,由病毒表達和細胞轉化而來。病毒的靶細胞是T淋巴細胞。tax蛋白對病毒複製十分重要,因其通過對5′長末端重複片段(5LTR)的作用刺激病毒mRNA轉錄。tax蛋白也能激活宿主細胞基因的轉錄,如c-fos基因和c-sis基因等,直接引發T細胞增生。
HTLV1型病毒感染和ATLL有著密切的關係。癌細胞含有HTLV1型病毒基因組。ATLL是一種慢性骨髓增生性疾病,全身淋巴結腫大、肝脾腫大、皮膚損害、高血鈣、骨囊腫和免疫缺陷等。HTLV1型病毒導致白血病,尚需第二致癌因子參與。HTLV1型病毒主要流行於日本西南部、北大洋洲和加勒比海域,日本有120萬人受到感染。ATLL病人有80%~90%存在HTLV1型病毒抗體。感染HTLV1型病毒的人中只有1%~4%發展為ATLL,潛伏期為幾十年。病人的預後很差,確診後的生存期只有幾個月。同一家庭內有多例病人發生,家庭內生活上密切接觸存在水平傳播的可能性。HTLV1型病毒的傳播可能存在多種形式,包括性接觸、輸血、節肢運動叮咬、注射和母嬰間哺乳傳播等。
1.2HIV 與淋巴瘤 (lymphoma)。HIV是一種人類逆轉錄病毒,包括HIV1型、HIV2型和HIV3型,有編碼毒粒結構蛋白的gag、pol和env三個基因。env編碼糖蛋白,成為gp41的跨膜蛋白和gp120的外膜蛋白。gp120蛋白能與T4抗原受體結合,嗜輔助性T4淋巴細胞,還能感染抗原呈遞細胞,刺激巨噬細胞產生淋巴組織增生的細胞因子如IL-6和IL-10等,使淋巴結內濾泡生髮中心過度增生。機體免疫反應受到嚴重抑制,發生侵襲性B細胞淋巴瘤。
1.3 HIV 與卡波氏肉瘤 (kaposi ′ s sarcoma , KS)。KS是一種多發性血管瘤,常累及內臟,導致病人窒息和胃腸出血而死亡,常在HIV感染的同性戀和雙性戀的人中見到。KS的發生尚需某種輔助因子的參與,內皮細胞所控制的某些因子也可能導致缺失,失去控制的內皮細胞通過非特異性刺激而激活和增殖。HIVtat基因產物tat蛋白作用於HIV感染細胞後,細胞產生的細胞因子也能加速KS生長。
2.DNA 病毒
2.1 EBV 與 Burkitt 淋巴瘤 (burkitt ′ s lymphoma , BL)。BL是一種流行於非洲東部兒童頷部的腫瘤。大多數人都感染過EBV,為什麼BL只在非洲局部地區流行?瘧原蟲感染可能是致癌的輔助因素,逆轉錄病毒(如HTLV1型和HTLV3型)在該地區傳播也可能有關。因為瘧疾損傷免疫監視和刺激網狀內皮系統。EBV是雙鏈線狀DNA病毒,含有衣殼抗原(VCA)、膜抗原(MA)、早期抗原(EA)和核抗原(EBNA)等。EBV是一種親淋巴性的皰疹病毒,經口傳播。在多數人中,病毒長期隱匿感染,而無致癌危險。在腫瘤細胞中能發現EBV的DNA序列和編碼蛋白質,80%腫瘤細胞有EBV核抗原,少數腫瘤細胞有EBV膜抗原。純化的EBV對體外培養的正常淋巴細胞可誘導惡性轉化,並將轉化細胞接種於該細胞來源的動物,可引發惡性腫瘤。EBV與B細胞DNA整合可激活c-myc和HuBlym-1癌基因,c-myc和HuBlym-1的表達失控導致細胞無限增殖。EBV持續感染刺激細胞生長,更加劇癌細胞形成。
2.2 EBV 與鼻咽癌 (nasopharyngeal carcinoma , NPC)。NPC為上皮細胞癌,EBV在體內能感染咽喉部B淋巴細胞。從NPC病人的腫瘤細胞已分離出感染性EBV。組織病理學上無論是屬於鱗狀細胞癌、非角化癌,還是未分類癌,在NPC組織標本中均能檢測到EBVDNA[3]。用EBVDNA作探針,C3d受體(C3dR)為EBV受體,EBV/C3dR的基因位於人類1號染色體長臂上。EBV一旦被激活,產生有感染性的EBV顆粒,可促使NPC發生。用轉基因動物作研究,也證實了EBV為NPC的病因。將EBV感染人鼻咽黏膜細胞,並移植至裸鼠,在TPA和丁酸的協同作用下,誘發出未分化癌,這是EBV能誘發人鼻咽部上皮細胞癌變的直接證據,表明EBV在鼻咽癌發生中起病因作用。
2.3 HHBV 與肝細胞癌 (human hepatocellular carcinoma , HHCC)。HHBV由外層脂蛋白包膜、核衣殼和3.2kb的DNA組成。包膜含有HBsAg,核衣殼由HBeAg組成,DNA為部分雙鏈。雙環的外環為長鏈(負鏈),與mRNA互補,有缺口,其5′末端有一共價蛋白。內環為短鏈(正鏈),只有長鏈的50%~75%,其3′末端與DNA多聚酶結合。在肝細胞內以游離和整合的形式存在。在HHBVDNA長鏈上有4個ORFS區(S基因)編碼病毒表面包膜蛋白和HBsAg;C區(C基因)編碼核衣殼的多肽——病毒核心蛋白、HBcAg和HBeAg;P區為模板,通過mRNA,編碼DNA多聚酶;X區(X基因)為模板,編碼的蛋白為154個胺基酸的X蛋白,X蛋白是病毒基因的轉錄調節因子,在體外細胞培養時能夠調節病毒基因的表達,引起宿主細胞基因突變或重排,使表達失常。並干擾宿主細胞生化代謝,影響細胞基因的正常表達,激活受染肝細胞原癌基因,而誘發HHCC。HHBV導致的肝損傷使肝細胞不斷再生,這使其它致癌因素的作用增強。有半數HHCC病人發生染色體17p缺失,伴有p53基因突變,p53蛋白失活。因p53基因是一種抑癌基因,從而導致HHCC發生。X蛋白具有絲氨酸/蘇氨酸蛋白激酶活性,有反式激活作用。反式激活其它病毒基因和細胞基因,如HHBV啟動子和增強子,即c-myc、c-fos和c-jun啟動子,故X蛋白為反式激活轉錄蛋白。X蛋白通過激活c-myc等多種細胞癌基因表達增強,刺激肝細胞生長。HHBV在體外難以培養,實驗室都用土撥鼠、地松鼠和鴨研究HHBV與HHCC的關係。
2.4 HPV 與宮頸癌 (cervical carcinoma)。HPV6、11、15、16、18、31、33、35、42、45、56、58和68型能感染女性生殖道,引發性傳播,如尖銳濕疣,能引發皮膚和黏膜鱗狀上皮增生及宮頸組織壞死。HPV16、18、31和45型與宮頸癌的關係甚為密切,85%宮頸癌及其癌前病變中發現HPV16和18型的DNA序列,其中70%為鱗狀細胞癌,15%為腺癌。HPV16或18型的DNA可整合到宿主細胞的DNA中。用分子雜交技術從宮頸癌組織刮取的細胞和宮頸癌的細胞株均能檢出HPV。HPV18型DNA在宮頸癌細胞株(SW756、C4-1、Hela細胞)中表達也獲得了實驗室證實。在人體細胞記憶體在一類與癌基因對立的抑癌基因,如RB基因(視網膜母細胞瘤基因)和p53基因 (p53基因位於人17p13-1q染色體上),相應編碼Rb蛋白和p53蛋白,均具有抑制細胞生長和促進細胞分化作用。HPV16和18型病毒E1、E6、E7基因編碼的E1、E6、E7蛋白能與Rb蛋白、p53蛋白結合,使Rb蛋白和p53蛋白變性,失去對腫瘤抑制作用,從而促使細胞轉化,導致細胞增殖和癌變。
宮頸癌是最常見的婦科腫瘤之一,發病率僅在乳腺癌之下。宮頸癌的發生與性行為有關,多見於多性伴人群,腫瘤細胞侵襲子宮頸基質、子宮、陰道和子宮旁組織,沿淋巴轉移至盆腔,沿血行轉移至肺、肝、骨和腦。用桿狀病毒表達系統獲得的VLP(virus like particles)製成HPV疫苗前景良好。疫苗能有效預防HPV感染,對早期感染者也有治療作用。HPV16型L1蛋白50μg肌注志願者能誘導機體產生高滴度中和抗體。

